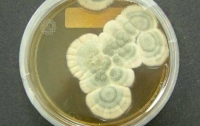
Историческую плесень в банке продали на аукционе за $15 тысяч

ВСЕ НОВОСТИ
-
 16:31 Здоровье
16:31 Здоровье
Ученые намерены получить новые лекарства изучая процессы в сыре с плесенью
-
 19:32 Наука и техника
19:32 Наука и техника
Ученые нашли уникальную плесень-убийцу пластика
-
21:28 Мир
21:28 Мир
Историческую плесень в банке продали на аукционе за $15 тысяч
-
 12:19 Мир
12:19 Мир
90-летнюю плесень продали за 15 тысяч долларов
-
10:44 Наука и техника
Исследователи доказали наличие интеллекта у плесени
-
 12:22 Здоровье
12:22 Здоровье
Сырость и плесень в доме крайне опасны для здоровья, - ученые




